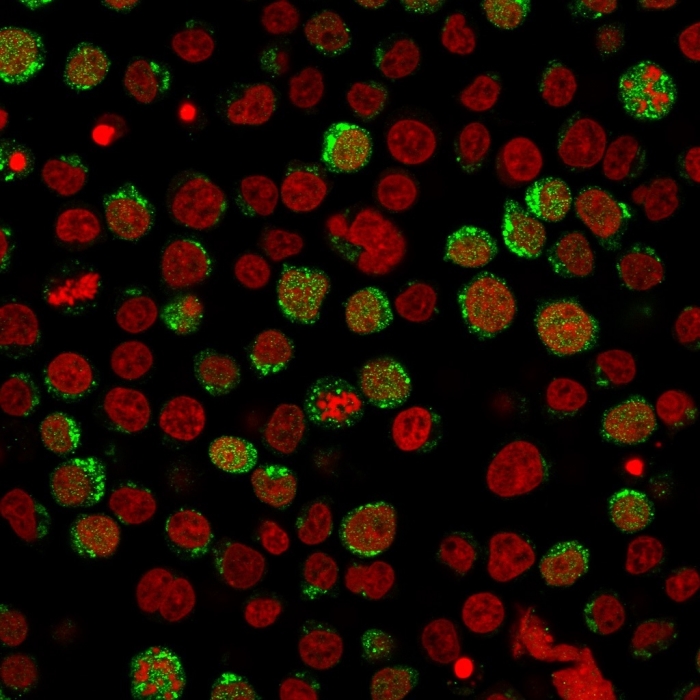

Flow Cytometric Analysis of Jurkat cells using CD40L-Monospecific Mouse Monoclonal Antibody (CD40LG/2761) followed by Goat anti-Mouse IgG-CF488 (Blue); Isotype Control (Red).
Immunofluorescent staining of paraformaldehyde-fixed Jurkat cells using CD40L Mouse Monoclonal Antibody (CD40LG/2761) followed by goat anti-Mouse IgG conjugated to CF488 (green). Nuclei are stained with Reddot.

SDS-PAGE Analysis Purified CD40L Mouse Monoclonal Antibody (CD40LG/2761). Confirmation of Purity and Integrity of Antibody.

Analysis of Protein Array containing more than 19,000 full-length human proteins using CD40-Ligand Mouse Monoclonal Antibody (CD40LG/2761) Z- and S- Score: The Z-score represents the strength of a signal that a monoclonal antibody (MAb) (in combination with a fluorescently-tagged anti-IgG secondary antibody) produces when binding to a particular protein on the HuProtTM array. Z-scores are described in units of standard deviations (SDÂ’s) above the mean value of all signals generated on that array. If targets on HuProtTM are arranged in descending order of the Z-score, the S-score is the difference (also in units of SDÂ’s) between the Z-score. S-score therefore represents the relative target specificity of a MAb to its intended target. A MAb is considered to specific to its intended target, if the MAb has an S-score of at least 2.5. For example, if a MAb binds to protein X with a Z-score of 43 and to protein Y with a Z-score of 14, then the S-score for the binding of that MAb to protein X is equal to 29.
CD40LG expression is mainly confined to the CD4-positive-T-cell subset. Its expression is induced shortly after T-cell activation and represents an early activation marker of T lymphocytes. CD40 is constitutively expressed mainly on B cells, macrophages, and dendritic cells. The CD40-CD40L pathway has been shown to play multiple functional roles in the healthy immune system. It enhances the antigen-specific T-cell response through the activation of dendritic cells and the induction of interleukin-12 production. For example, engagement of CD40 on endothelial cells by activated T cells expressing CD40L leads to upregulation of adhesion molecules such as ICAM-1, VCAM-1, and E-selectin. Activation of APC by CD40-CD40L interaction induces the production of inflammatory cytokines, chemokines, NO, and metalloproteinases. Interaction of CD4-positiveCD40LG-positiveT cells with CD40 on B cells leads to B-cell differentiation, proliferation, immunoglobulin (Ig) isotype switching, and formation of memory B cells.
There are no reviews yet.